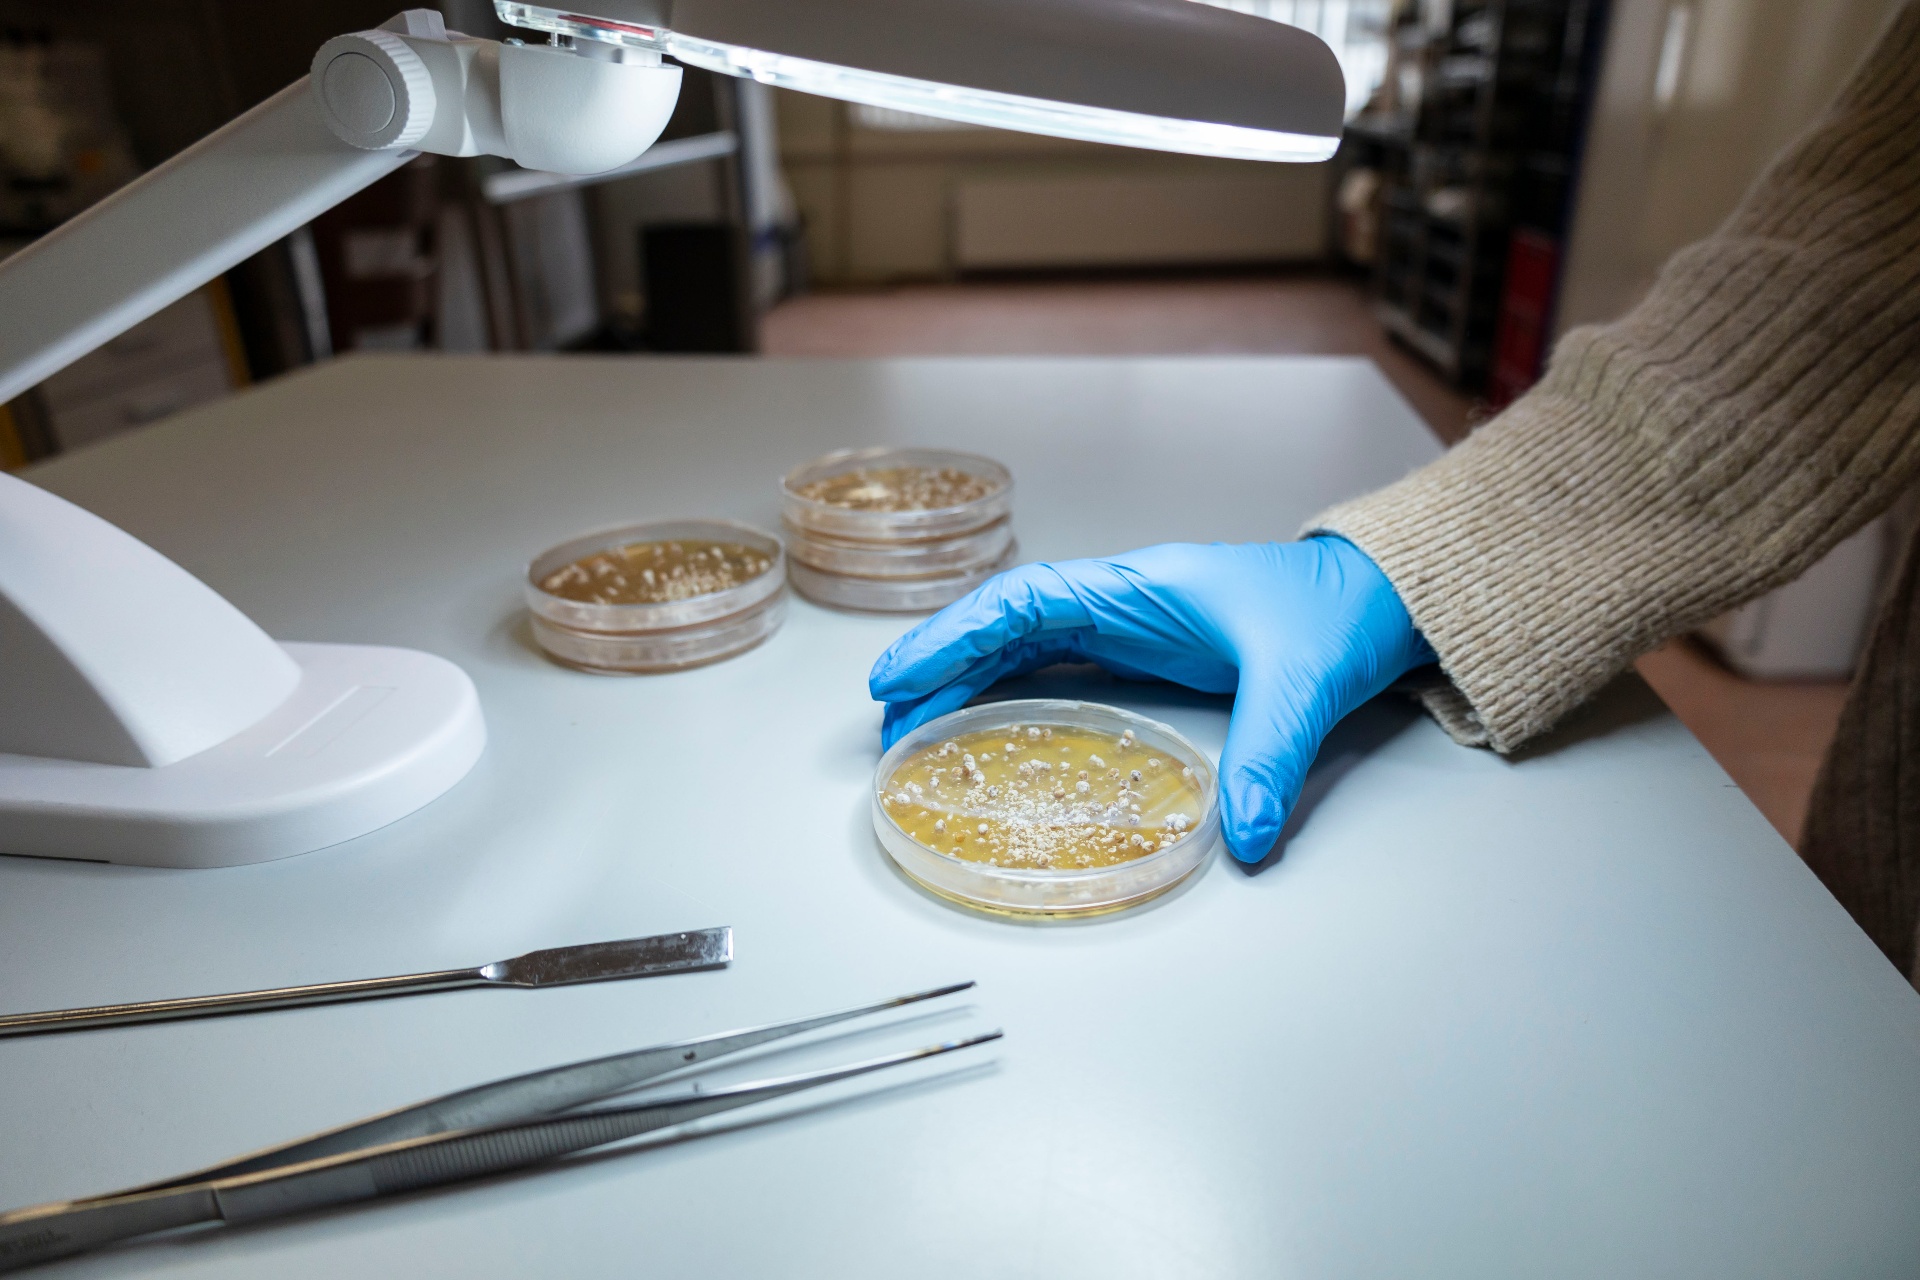

100+ jaar familiegeschiedenis
Een eeuwvakmanschap.
Wij combineren meer dan een eeuw familie-ervaring met gecontroleerde biotechnologie, zodat telers wereldwijd kunnen rekenen op broed dat presteert.
Over Ons
Meer dan startmateriaal.
OurCelia ontwikkelt en produceert hoogwaardig champignonbroed voor professionele teelten, aangevuld met bredere toepassingen rond mycelium en biostimulanten, als onderdeel van de Scelta Mushrooms-familie, voortbouwend op meer dan een eeuw praktijkervaring in de paddenstoelensector.
Ons uitgangspunt: broed is geen commodity. Het is de basis van elke teelt, en daarmee een directe factor in uw opbrengst, stabiliteit en procesbeheersing. Daarom produceren wij onder strikt gecontroleerde farmaceutische omstandigheden, met een sterke focus op hygiëne, reproduceerbaarheid en kwaliteitsborging.
Meer over OurCelia

Onze Aanpak
Precisie in elke stap.
Professionele champignonteelt vraagt om betrouwbaarheid, batch na batch. Bij OurCelia is dat geen loze belofte, maar een ingesleten en gecontroleerd productieproces.
Stamselectie
Zorgvuldige selectie van sterke myceliumlijnen, geschikt voor diverse klimaatomstandigheden en teeltsystemen. Gericht op stabiele prestaties en voorspelbare resultaten.
Ontwikkeling van drager recepturen
Consistente, voedingsrijke substraten die optimale kolonisatie ondersteunen. Samengesteld met oog voor interactie met de compost en microbiologisch evenwicht.
Gecontroleerde Productie
Van labmonster tot bulklevering: elke batch wordt geproduceerd onder gestandaardiseerde omstandigheden met volledige kwaliteitsborging en traceerbaarheid.
Onze Productieprocessen
Onze productieprocessen zijn high-care en voldoen aan farmaceutische standaarden. Dat betekent:
- Steriele omgevingen met gecontroleerde luchtstromen
- Microbiologische monitoring en kwaliteitsborging
- Traceerbare batches en datagedreven optimalisatie
- Validatie van substraten en inoculatieprocessen
- Op ISO-gebaseerde protocollen voor hygiëne, temperatuur, vochtigheid en luchtkwaliteit

Onze Producten
Betrouwbare broed- en substraatoplossingen voor professionele teelt. Van champignonbroed tot myceliumtoepassingen en biostimulanten.
Innovatie & Onderzoek
Broed als startpunt voor innovatie.
Bij OurCelia combineren we decennia aan praktijkervaring met gecontroleerde biotechnologie. Onze R&D richt zich op het begrijpen en verbeteren van de biologische processen die bepalend zijn voor een succesvolle teelt.
Onze focusgebieden:
Stabiliteit van het teeltproces
Efficiënter gebruik van grondstoffen
Substraatoptimalisatie en microbiologisch evenwicht
Ketenintegratie, met als focus het eindresultaat
"Continue verbetering door biotechnologie."
Vanuit deze kennis is ook FungiPower ontstaan, onze productlijn die biologische processen in de champignonteelt actief ondersteunt en zorgt voor een beter rendement.


Kennispartner voor telers die vooruit willen.
OurCelia denkt mee. Van substraat en proces- tot klimaatbeheersing: wij zijn klaar om met u in gesprek te gaan.
Belangrijk onderscheidend vermogen: flexibiliteit, ketensamenwerking en biotechnologische diepgang. OurCelia blinkt uit in een diepgewortelde kennis van de paddenstoelenbiologie gecombineerd met innovatiekracht.
Neem Contact Op